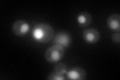
YDR361C
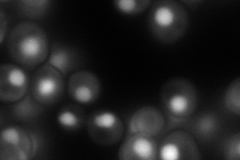
YDR361C
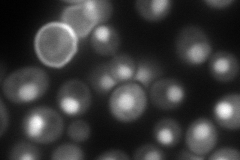
YDR361C
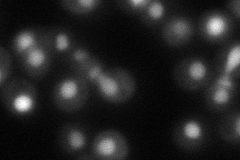
YDR361C
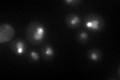
YDR361C
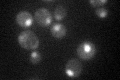
YDR361C

View description
Essential protein involved in nuclear export of Mss4p, which is a lipid kinase that generates phosphatidylinositol 4,5-biphosphate and plays a role in actin cytoskeleton organization and vesicular transport
Localization:
Intensity:
Fold change:
Significance:
-
C’ GFP library in SD
nucleus86.33 -
N' NOP1pr-GFP in SD
nucleus174.894 -
N' TEF2pr-mCherry in SD
nucleus210.352 -
N' NATIVEpr-GFP in SD
nucleus69.7183 -
N' TEF2pr-VC and Cyto-VN in SD

#N/A0 -
C’ GFP library in SD+DTT
nucleus60.30.69No -
C’ GFP library in SD+H2O2

nucleus72.410.83No -
C’ GFP library in Starvation Media
nucleus45.790.53Yes -
C’ GFP library on the background of Pup2-DaMP

nucleus -
C’ GFP library on the background of CCT mutant

nucleus75.45440.873946No
